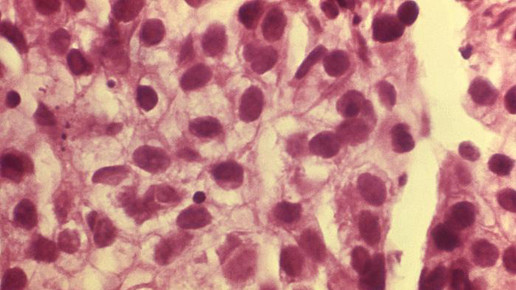
Magnet-Roboter macht Hoffnung gegen Krebs

Magnet-Roboter macht Hoffnung gegen Krebs
Mit einem zwei Tonnen schweren Magnet-Roboter sollen künftig Krebszellen effektiver bekämpft werden können. Mittels winziger Nanopartikel leitet die derzeit in einem Forschungsprojekt am Universitätsklinikum Erlangen erprobte Maschine Medikamente präzise an ihr Ziel, ohne umliegendes Gewebe zu zerstören, wie der Leiter der Sektion für Experimentelle Onkologie und Nanomedizin (Seon), Professor Christoph Alexiou, heute mitteilte. Damit würden zum Beispiel Chemotherapien deutlich effektiver und ihre Nebenwirkungen viel geringer als heute.
In der Nanomedizin werden Eisenoxidpartikel so klein wie der millionste Teil eines Millimeters als Transportmittel für Medikamente eingesetzt, sagte Alexiou. Über einen Katheter werden die Teilchen dem Patienten injiziert. Die Magnetspitze des Roboters führt die Eisenoxidteilchen dann genau an die Stelle, an der das Medikament wirken soll. Auch im Kampf gegen Arteriosklerose und gegen Herz-Kreislauf-Krankheiten soll der halbautomatische Roboter eingesetzt werden.
Die als Prototyp gebaute Maschine ist nach Angaben der Klinik die erste ihrer Art weltweit und wird während des Zulassungsverfahrens an menschlichen Dummies getestet. Finanziert wird die Forschungsstelle am Uniklinikum Erlangen durch den Bund, den Freistaat Bayern und durch Stiftungen.

APOTHEKE ADHOC Debatte